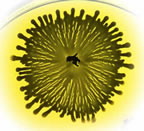

| Kokus |

Kokus |

Kokus |

Kokus |

Kokus |

Kokus |
Tek tek ya da koloni şeklinde bulunabilen, yuvarlak şekilli bakterilerdir. Tek tek olanlarına kokus (coccus) denir. |
| Kokus |
Kokus |

Kokus |

Kokus |

Kokus |

Kokus |
Tek tek ya da koloni şeklinde bulunabilen, yuvarlak şekilli bakterilerdir. Tek tek olanlarına kokus (coccus) denir. |